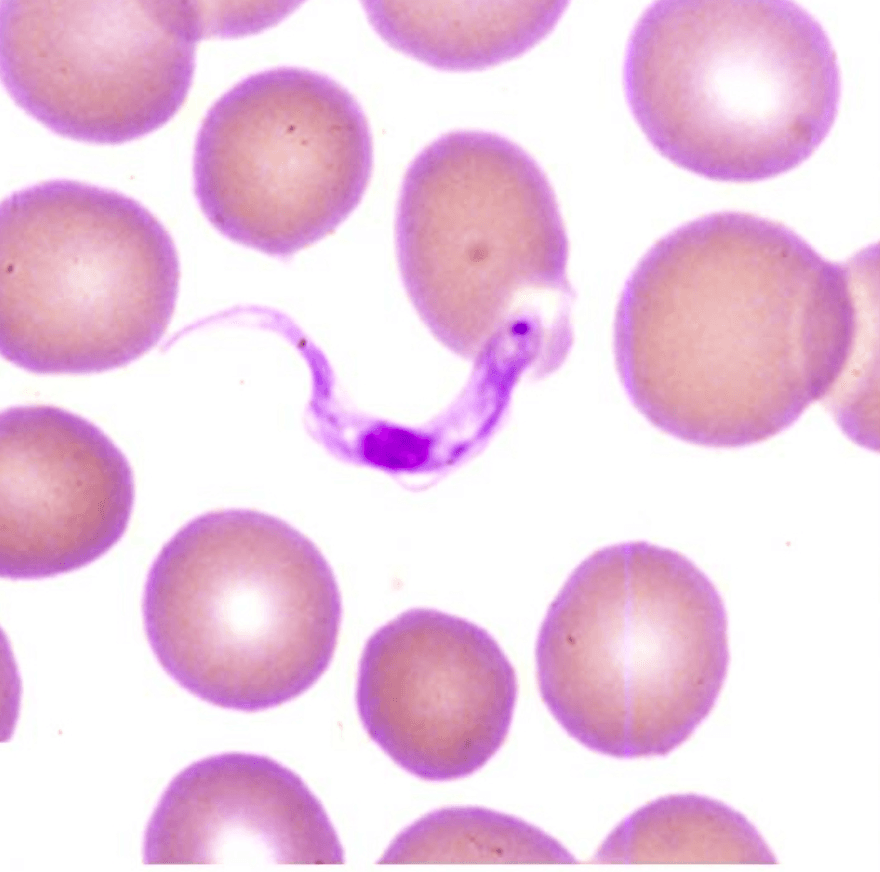
Peripheral blood smear showing trypomastigotes among red blood cells

The Long Way Home
Clinical Vignette
A 34-year-old woman with no prior medical history presents to a travel medicine clinic two weeks after returning from an 18-month deployment as a humanitarian aid worker in the Democratic Republic of Congo, where she worked in a rural area near the Kasai River. She reports six weeks of intermittent fever, drenching sweats, generalized headache, and profound fatigue. Over the past two weeks, her colleagues noticed personality changes and increasing confusion. She describes sleeping for much of the day and lying awake through the night. When prompted, she recalls a painless, erythematous nodule on her left forearm that appeared within the first month of her deployment, became mildly itchy, and resolved spontaneously over two to three weeks. She took malaria prophylaxis inconsistently.
On examination, temperature is 38.2°C, heart rate 96, blood pressure 112/70 mmHg. She is oriented to person and place but not to date. There is bilateral, rubbery, non-tender posterior cervical lymphadenopathy, more prominent on the left. No axillary or inguinal lymphadenopathy. No skin lesions are present on examination. Mild psychomotor slowing is noted. Neurological examination reveals no focal deficits but her Mini-Mental State Examination score is 22 of 30.
Laboratory studies: hemoglobin 10.2 g/dL, WBC 7.4 k/mcL, platelets 188 k/mcL. ESR 94 mm/hr. LFTs mildly elevated. Rapid malaria antigen test is negative. A thin peripheral blood smear is prepared and the image below is obtained.
Peripheral blood smear from the patient: an extracellular organism is identified among red blood cells.
Question 1
What is the most likely diagnosis?
Select one option to submit your answer and view live poll results.
Question 2
What is the most critical next step before initiating treatment?
Select one option to submit your answer and view live poll results.
Question 3
The lumbar puncture confirms stage 2 disease. What is the first-line treatment?
Select one option to submit your answer and view live poll results.
References
Lutje V, Seixas J, Kennedy A. Chemotherapy for second-stage human African trypanosomiasis. Cochrane Database of Systematic Reviews. 2013;(6):CD006201.
Bisser S, Lumbala C, Nguertoum E, et al. Sensitivity and specificity of a prototype rapid diagnostic test for the detection of Trypanosoma brucei gambiense infection. PLOS Neglected Tropical Diseases. 2016;10(4):e0004608.
Lindner AK, Lejon V, Barrett MP, et al. New WHO guidelines for treatment of gambiense human African trypanosomiasis including fexinidazole: substantial changes for clinical practice. The Lancet Infectious Diseases. 2020;20(8):e227-e238.